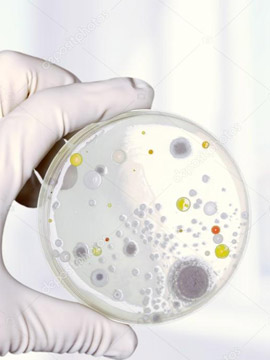
wind damage

Licensed Mold Remediation in DFW
The Dalworth Mold Remediation Process
-
01
Our team does a visual inspection of your property to assess the extent of mold growth & evaluate the scope of the issue.
-
02
Next, we work with a industrial hygentist to determine the type of mold growth & count. The results are analyzed by a qualified lab that speciflizes in mold testing.
-
03
Once testing is complete, the Dalworth Mold team develops & executes a mold remediation plan that brings mold levels back to a healthy state.
-
04
After remediation, we rebuild the property to its original condition. We will also provide a prevention plan to keep mold growth from re-appearing!
Why Choose Dalworth Mold




What Others Said About Us
On a scale of 1-10 with 10 as the highest, I'd give Dalworth an 11!

Kristi B Dallas, TX
Dalworth seemed to take a lot of pride in their work and it shows. I would recommend your company to anyone in this situation in the future.

Wilma H Dallas, TX
My tenant was complaining about reoccurring mold in the shower. I called Dalworth to check it out for me. Dalworth gave me valuable suggestions.